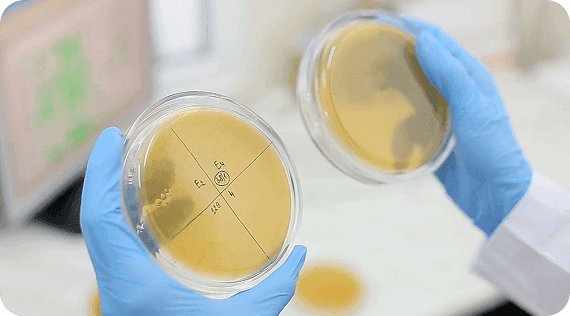
product background

"We have been using the same technology to detect infection for 100 years.... The rest of medicine is advancing but we have remained stagnant.... Next-Generation sequencing is the next level when it comes to diagnosis."
Dr. Cliff Martin, Infectious Disease
Traditional culture methods have limitations
Traditional microbiological culture methods, while long established, have significant limitations that can impact the accuracy and efficiency of diagnosing infectious diseases. These limitations include:
- High false-negative rates, particularly in patients pre-treated with antibiotics
- Inability to culture many clinically relevant bacteria and fungi, including anaerobes and fastidious organisms
- Limited recovery of organisms within biofilms, which are common in chronic and prosthesis-associated infections
The challenge of detecting biofilms
Biofilms are complex communities of microorganisms embedded in a self-produced extracellular matrix, pose a significant challenge for culture-based diagnostics.
Microbes in biofilms often in a dormant state and show increased tolerance to antibiotics, making them difficult to detect using standard culture methods.
Chronic infections such as non-healing wounds, chronic rhinosinusitis, recurrent UTIs, and prosthesis-associated infections are frequently linked to biofilms that are missed by conventional diagnostics.

Our Technology: Decoding Microbial DNA from Samples

We extract DNA from bacteria and match it to a library that identifies the species through Next Generation Sequencing (NGS).
Sequencing does not require growth of a microbe. Because all microbes have unique DNA, it can be extracted directly from any sample type. DNA can be used like a fingerprint! DNA is also highly stable. Our stability testing shows samples remain viable at room temperature for at least 21 days after collection.
Evidence Based Treatments to fight against Antimicrobial Resistance (AMR)
By accurately identifying the microorganisms in an infection, our test enables clinicians to select the most appropriate evidence-based treatments. By guiding the selection of the most appropriate antibiotics, our test supports targeted therapy. This precision limits broad-spectrum antibiotic use and helps prevent the rise and spread of resistant organisms.

The Power of Next Generation Sequencing
Next Generation Sequencing (NGS), also known as high-throughput sequencing, enables the simultaneous sequencing of millions of DNA fragments, providing comprehensive insight into the microbial content of a patient sample. Unlike PCR tests, NGS does not require prior knowledge of the target species, organisms are identified directly through their DNA sequences. With NGS, billions of template strands are sequenced simultaneously, which greatly increases the throughput, speed and accuracy.

Our Laboratory Process
Cutting edge molecular diagnostics for superior accuracy of results

Two-Step DNA Extraction
Tailored to the Sample. Each specimen is processed differently ensuring we begin with the most concentrated material.
Mechanical Lysis (step 1). We use beads technology to break tough microbial cells (bacteria, yeast, fungi), avoiding harsh chemicals and ensuring maximum DNA release.
Automated DNA Purification (step 2). Lysed samples go through an automated system that removes proteins, inhibitors, and human DNA leaving clean microbial DNA for sequencing.
Strict Quality Controls. Every run includes positive and negative controls to confirm extraction success and detect contamination—ensuring accuracy and reliability.